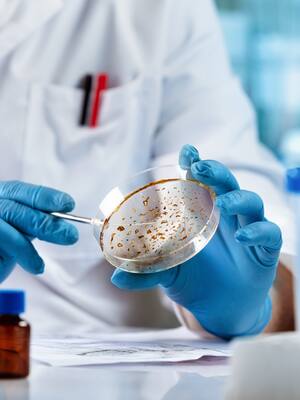
Bacterias amenazan los olímpicos | Columna de Álvaro Villanueva

La contaminación de aguas, definida como la acumulación de una o más sustancias ajenas al agua puede ocasionar una gran cantidad de consecuencias, que altera la vida, no solo de los humanos sino también de otros seres vivos.
El reino monera es el de las bacterias, que no vemos por su reducido tamaño, solamente observadas a través del microscopio y de sus efectos, que pueden ser favorables o devastadores.
Las bacterias que amenazan los juegos olímpicos no solo afectan países pobres sino también a los ricos, como es el caso de las infecciones contaminantes del río Sena en París.
Después de que la atleta Claire Michel, necesitará una atención hospitalaria de urgencias, por haber adquirido una infección bacteriana, durante la competencia del 31 de julio en el triatlón femenino, cuando nadó por el río Sena, la salubridad de este río famoso desde la antigüedad, vuelve a ser cuestionable y podría representar un riesgo para los competidores. El reconocimiento de niveles aumentados de E. coli y/o Enterococos, dos bacterias, utilizadas para confirmar la contaminación del agua, han puesto en duda la posibilidad de realizar competencias programadas, para lo que se han venido preparando desde hace ya varios meses. Lograr el saneamiento del río, permanece como un verdadero reto para el éxito de los juegos. Las autoridades invirtieron más de 1.400 millones de euros, aproximadamente 1.520 millones de dólares al cambio actual en la creación de una serie de infraestructuras necesarias y obligatorias, que permita la utilización del río para reducir la contaminación en el Sena.
Anteriormente en agosto de 2023, las pruebas de ensayo de triatlón se anularon, en parte por la insuficiente calidad del agua para los estándares europeos respecto a dos bacterias que indican contaminación con materias fecales, la “Escherichia coli” y los enterococos.
El pasado 31 de julio, el presidente de Francia, Emmanuel Macron, celebró la disputa de las pruebas, con en un mensaje en la red social X, ilustrado con imágenes de triatletas lanzándose al río, y el texto: “Con una inversión masiva del Estado, conseguimos en cuatro años lo imposible desde hace 100 años: se puede nadar en el Sena”, una “fabulosa herencia” para los habitantes “y la biodiversidad”.
La humanidad, no ha aprendido a vivir entre humanos y mucho menos, compartir con otros seres vivos, necesarios para lograr al menos un equilibrio necesario para la vida, gracias a una participación de seres tan pequeños como las bacterias, que en ocasiones nos favorecen como en el caso de la microbiota o bacterias, que hacen posible, numerosas funciones para la vida.
Algunas bacterias permiten digerir los alimentos, destruir células causantes de enfermedades y suministrar vitaminas al cuerpo. Las bacterias se pueden utilizar para fabricar alimentos saludables como el yogurt y el queso. Pero también infecciones severas, capaces de ocasionar la muerte de otros seres vivos. Incluyendo virus y hongos, esto último con la utilización de fabricar vacunas, las hacen seres indispensables para la vida.
Pueden ocasionar grandes epidemias o pandemias como en el caso del cólera.
El problema de su presencia en el río Sena, nos lleva a pensar, en la gran necesidad de realizar un manejo serio y puntual de nuestros ríos. Ojalá, nos sirva de lección, reflexión y reacción, para establecer un apropiado manejo de nuestras aguas.